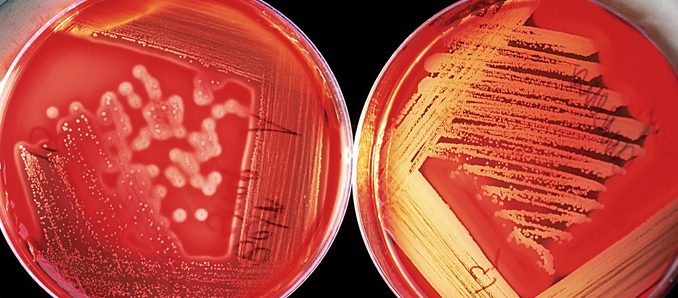

Im vergangenen Sommer hat sich eine Studentin der Hochschule Fulda im Rahmen ihrer Masterarbeit mit dem Thema „Multiresistente Erreger“ (MRE) in Gesundheits- und Pflegeeinrichtungen des Vogelsbergkreises befasst: „Auch wenn aus methodischen Gründen die Ergebnisse nicht vollständig generalisierbar sind, weil die Antwortquote nur bei knapp 50 Prozent lag, kann gesagt werden, dass die MRE-Häufigkeit dem Landesdurchschnitt entspricht und die Hygienemaßnahmen in den Einrichtungen des Vogelsbergkreises den allgemeinen Standards der MRE-Netzwerke entsprechen.“ So lautet das Fazit von Maren Vehling.
Begleitet wurde ihr Projekt von Prof. Dr. Thilo Schlott aus dem Fachbereich Pflege und Gesundheit der Hochschule Fulda. Experten aus der Region sehen die MRE-Situation dennoch als stetige Herausforderung für das medizinische Fach- und Pflegepersonal.
Dr. Henrik Reygers, kommissarischer Leiter des Vogelsberger Gesundheitsamts, plädiert schon seit langem für einen verantwortungsvollen Umgang mit Antibiotika: „Seit Jahren schon führen zu häufige und wenig umsichtige Einnahmen dazu, dass Bakterien mit klassischen Antibiotika nicht mehr auszumerzen sind, sich also Resistenzen entwickeln. Sie stellen ein ernstzunehmendes Problem für die öffentliche Gesundheit dar.“ Er setzt gemeinsam mit seiner Mitarbeiterin Dr. Elisa Stickler und den Mitgliedern des MRE-Netzwerks Mittelhessen auch auf Patientenaufklärung, denn: „Schon einfache Maßnahmen wie zum Beispiel eine konsequente Händehygiene kann dabei helfen, einer weiteren Ausbreitung von MRE vorzubeugen.“
Das MRE-Netzwerk Mittelhessen wurde 2012 gegründet. Ihm gehören die Uniklinik Gießen, das Regierungspräsidium und seine fünf zugehörigen Landkreise an. Aufgabe des MRE-Netzwerk ist es, das Fachwissen verschiedener medizinischer und pflegerischer Einrichtungen der Region Mittelhessen für die Bekämpfung der multiresistenten Erreger zu bündeln.
Zum Hintergrund: Laut einer Hochrechnung im Rahmen einer Studie zur Entwicklung multiresistenter Keime (veröffentlicht im Fachblatt „The Lancet Infectious Diseases im November 2018) haben sich 2015 EU-weit mehr als 670.000 Patienten mit multiresistenten Erregern infiziert, für 33.000 Patienten endete die Infektion tödlich. Besonders gefährdet seien Kleinkinder unter einem Jahr und ältere Menschen über 65 Jahre. Für Deutschland rechnen die Forscher statistisch mit fast 55.000 Infektionen mit multiresistenten Keimen und mehr als 2300 Todesfällen. Gemessen an der Bevölkerungszahl landet Deutschland damit im unteren Mittelfeld. Etwa drei Viertel der Erkrankungen mit antibiotikaresistenten Keimen entstünden in Krankenhäusern und anderen Einrichtungen des Gesundheitssystems, berichten die Forscher weiter. In 39 Prozent der betrachteten Fälle seien die Patienten mit einem Keim infiziert, gegen den auch Reserve-Antibiotika nichts mehr ausrichten können. Die Behandlung einer Infektion ist dann nur noch schwer, teils gar nicht mehr möglich. +++ pm








